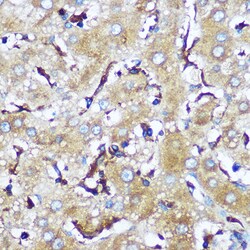
Invitrogen SERC1 Polyclonal Antibody 100 &mu;L; Unconjugated:Antibodies,
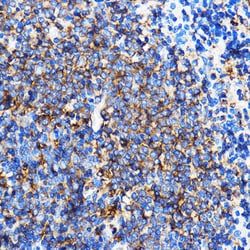
Invitrogen SERC1 Polyclonal Antibody 100 &mu;L; Unconjugated:Antibodies,

missing translation for 'onlineSavingsMsg'
Learn More
Learn More
Invitrogen™ SERC1 Polyclonal Antibody


Rabbit Polyclonal Antibody
Brand: Invitrogen™ PA5120644
This item is not returnable.
View return policy
Description
Positive test controls include: U-87MG, HepG2, HeLa. Immunogen sequence: ESTLIEDGGA RSDGSLEDGD DVHRAVDNER DGVTYSYSFF HFMLFLASLY IMMTLTNWYR YEPSREMKSQ WTAVWVKISS SWIGIVLYVW TLVAPLVLTN RDFD.
SERINC1, also named as KIAA1253, TDE1L and TDE2, belongs to the TDE1 family. SERINC1 enhances the incorporation of serine into phosphatidylserine and sphingolipids.
Specifications
| SERC1 | |
| Polyclonal | |
| Unconjugated | |
| SERINC1 | |
| 1500011D18Rik; AI315070; Aigp2; AIGP-2; axotomy induced glycoprotein 2; axotomy-induced glyco/Golgi protein 2; KIAA1253; LRRGT00191; Membrane protein TMS-2; mKIAA1253; Serinc1; Serine incorporator 1; Tde1l; Tde2; TMS2; TMS-2; tumor differentially expressed 1, like; tumor differentially expressed 2; Tumor differentially expressed protein 1-like; Tumor differentially expressed protein 2; UNQ396/PRO732 | |
| Rabbit | |
| Affinity chromatography | |
| RUO | |
| 294421, 56442, 57515 | |
| -20°C, Avoid Freeze/Thaw Cycles | |
| Liquid |
| ELISA, Immunohistochemistry (Paraffin), Western Blot | |
| 1.61 mg/mL | |
| PBS with 50% glycerol and 0.01% thimerosal; pH 7.3 | |
| Q7TNK0, Q9NRX5, Q9QZI8 | |
| SERINC1 | |
| A synthetic peptide corresponding to a sequence within amino acids 350-453 of human SERINC1 (NP_065806.1). | |
| 100 μL | |
| Primary | |
| Human, Mouse, Rat | |
| Antibody | |
| IgG |
Product Content Correction
Your input is important to us. Please complete this form to provide feedback related to the content on this product.
Product Title
Spot an opportunity for improvement?Share a Content Correction